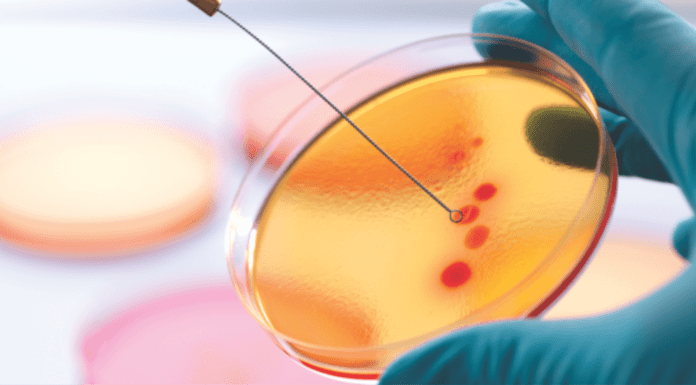
Report: Anti-microbial resistance analysis in Indian Aquaculture

IDMA Fair supported by 21 associations and unions
IDMA, which is the only international technology exhibition in grain and pulses processing industry, will be held in Istanbul Expo Center in Yeşilköy
between 04...
Top 20 Milk Processors collect 25.4% of produced milk worldwide
IFCN, the Dairy Research Network, recently released the actual IFCN Top 20 Milk Processor list. This list ranks the processor giants of the world...
Kemin global expansion continues in Belgium
Delivering on its global growth plans, Kemin opened a new state-of-the-art quality control lab and 14.600 square meters of warehouse and logistics office space at...
Reducing reliance on traditional ingredients
VICTAM, FIAAP & GRAPAS Asia has become a known brand name among Indian grain & feed industry. The event has recently concluded its 25th...
Growing importance of Canola meal for Indian Industry
Canola, a low-acid cultivar of rapeseed which was developed in Canada, and largely considered as Canada's most valuable oilseed, as the total value of...
2016 World Mycotoxin Forum focused on impacts of Climate change on...
2016 World Mycotoxin Forum addressed “Mycotoxins in a changing world” and the discussion revolve around undeniable impact climate change on mycotoxin contamination in the...
M-fodder–ICT based fodder innovation in Kenya
The smallholder dairy farmers in Kenya have very less land. Though they are involved in dairy farming, they cannot spare the land resources to...
India can reach 50 million tones maize output by 2025
India can double its maize production to 50 million tonnes (MT) by 2025 to meet the rising domestic demand of the crop, Agriculture Minister...
Feed samples from Asia-Pacific contaminated with heavy metals
Of the 1,375 samples of minerals, premix and complete feeds from 16 Asia-Pacific countries submitted for testing in the 2016 Alltech Asia-Pacific Heavy Metal...
Spine Less Cactus as Fodder for Livestock
Drylands comprise 40 % of the global land area and host more than 2 billion people. Ironically these areas are mostly overpopulated, thus increasing...
Maize demand on rise in Indonesia
Indonesia still needs to import maize as domestic production has not increased while demand for the commodity continues to increase, according to Indonesian Agribusiness...
Feed raw material imports bring prices of crops down in Thailand
Agricultural organizations will ask the Prime Minister to consider lowering the imports of wheat and corn gluten feed, which have caused their prices to...
Influence of feed and nutrients on Coccidiosis infection
Introduction
Adequate supply of finely balanced dietary nutrients is essential for optimal growth of modern fast growing meat birds owing to their high genetic potential....
Weather and lower prices to hit soya output
With the drought-like situation in the state and the monsoon uncertainty, many cultivating soybean till now plan to switch to other crops.
Maharashtra and Madhya...
Feeding aspects and other challenges faced by the Indian Dairy Industry
The socio-economic conditions in India render the Indian Dairy Industry in sharp contrast to the industrially advanced nations. The demand for milk and...
Maize Prices in India crossed industry expectations
The maize planting in the US is almost done and more than 72% of the corn has emerged. The weather looks good and with...
Animal feed from Cassava peel
With 60% of the world's arable land, Africa has the potential to not only feed itself, but also to become a major food exporter....
Nuscience strategic collaboration with Jubilant Life Sciences
Nuscience Group and Jubilant Life Sciences recently announced a strategic marketing collaboration agreement for the distribution of Nuscience products in India, Sri Lanka and...
G2F2 2016 to deliberate on the BIG ideas for Grain, Food...
Tefla’s is organizing 3rd edition of Global Grain Food & Feed ( G2F2 ) 2016 scheduled during at 9– 10-11 June, 2016, JW Marriott,...
Feed processing bringing increase profitability
Belgium: Many feed mill operators have done just about all they can to increase profitability through reducing input costs at the raw material level,...